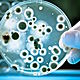
Noticias somich 8
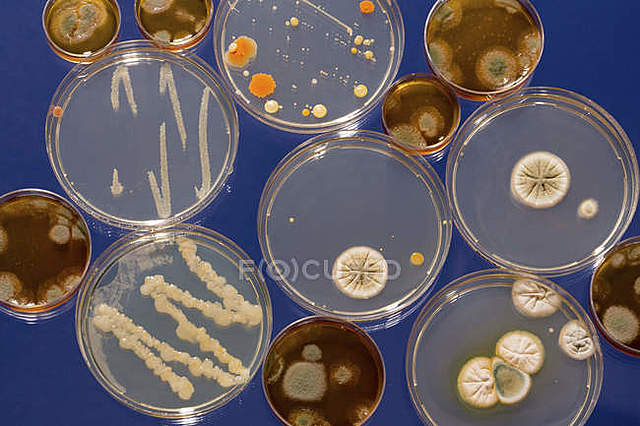
Richard Petri

-
Publico el libro Micrographia donde describió en detalle una serie de observaciones microscópicas ilustrando los cuerpos fructificantes de los mohos. Fue la primer descripcion de un microorganismo.
-
-
A través de su microscopio (simple con una sola lente),con cuidadosas manipulaciones y enfoques precisos observo por primera vez eritrocitos y bacterias comunes de diferentes formas como: A, C, F y G, bacilos; E, cocos; H, grupos de cocos.
-
Aplico técnicas de asepsia en la cirugía las cuales fueron una de las pruebas pruebas indirectas que formaron parte de la importancia de los microorganismos en el origen de las enfermedades humanas.
-
-
Descubrió la generación espontánea que constaba que, si se calentaba considerablemente una solución nutritiva y después se precintaba, esta no se pudría y se esterilizarla.
Él es quien creo el matraz de Pasteur. -
Fue el primero en identificar los gránulos como azufre y realizar una ilustración de esta bacteria filamentosa oxidante de azufre Beggiatoa mirabilis.
-
Realizo mejoras higiénicas para controlar las infecciones hospitalarias, las cuales fueron pruebas indirectas que dieron aportes a la microbiologia.
-
Estudio la resistencia de las bacterias al calor y descubrió la formación de endosporas por parte de algunas bacterias, donde pudo describir el ciclo vital de la bacteria formadora de endosporas bacillus. Además, concibió muchos métodos eficaces para prevenir la contaminación de los medios de cultivo.
-
Demostró que las bacterias nitrificantes y bacterias del azufre catalizan transformaciones químicas específicas en la naturaleza. Propuso el importante concepto de quimiolitotrofia, la oxidación de compuestos inorgánicos para obtener energía y descubrió que las bacterias quimiolitótrofas, al igual que los organismos fotosintéticos, son autótrofas.
-
-
Ambos comprendieron que los medios sólidos proporcionaban una forma fácil de obtener cultivos puros, que es una población de células idénticas, es decir, con una forma y un color característico.
-
Descubrió que la Mycobacterium tuberculosis es la bacteria que causa la tuberculosis. Este experimento y otros relacionados a descubrir los agentes causante de la mayoría de las enfermedades infecciosas importantes, fueron analizadas por los Postulados de Koch que son los que demuestran la relación de causa y efecto de las mismas enfermedades.
-
Desarrollo las vacunas contra el carbunco, el cólera aviar y la rabia
-
Inventó las placas transparentes de dos caras conocidas como placas de Petri, que se convirtieron rápidamente en la herramienta estándar para obtener cultivos puros.
-
Observó que el agente infeccioso solo se multiplicaba dentro de células vivas en división, pero como sus experimentos no mostraban que estuviera compuesto de partículas, lo llamó «germen viviente soluble» y reintrodujo el término «virus».
-
Luego del descubrimiento de Winogradsky del proceso de fijación de nitrógeno , formuló una técnica del cultivo de enriquecimiento en donde los microorganismos se aíslan de muestras naturales mediante nutrientes y condiciones de incubación muy selectivos para favorecer un grupo metabólico concreto de organismos
-
A partir de las bases de genética microbiana conocidas, la
microbiología experimentó un nuevo impulso, en donde se desarrollaron los nuevos campos de la biología molecular, la ingeniería genética y la genómica. Estas subdisciplinas moleculares han revolucionado las ciencias de la vida y han engendrado nuevas generaciones de herramientas experimentales con las que atacar los problemasmás complejos y desafiantes de la biología
Want to make a timeline like this?
Use Timetoast to turn dates, events, milestones, and phases into a clear visual timeline you can build and share. Timetoast is a timeline maker for work, school, research, and stories.